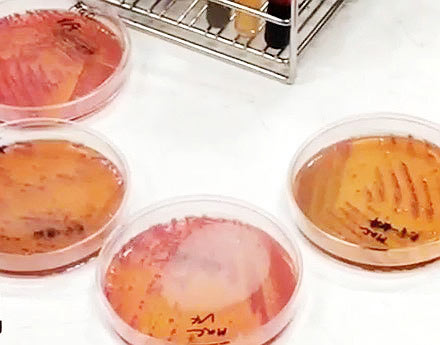
อึ้ง ! เผยผลตรวจน้ำส้มคั้นบรรจุขวด ไม่ผ่านเกณฑ์มาตรฐานทุกตัวอย่าง

สำนักคุณภาพและความปลอดภัยอาหาร เผยผลตรวจน้ำส้มคั้นบรรจุในภาชนะปิดสนิท 15 ตัวอย่าง ไม่ผ่านเกณฑ์มาตรฐานการตรวจคุณภาพทางเคมี-จุลชีววิทยาทุกตัวอย่าง
วันที่ 13 มิถุนายน 2559 สำนักคุณภาพและความปลอดภัยอาหาร กรมวิทยาศาสตร์การแพทย์ กระทรวงสาธารณสุข ได้เผยผลตรวจตัวอย่างน้ำส้มคั้นสดในภาชนะปิดสนิท โดยนายแพทย์อภิชัย มงคล อธิบดีกรมวิทยาศาสตร์การแพทย์ เปิดเผยว่า สำนักงานคณะกรรมการอาหารและยา ได้เก็บตัวอย่างน้ำส้มคั้นสดจากสถานที่จำหน่ายในเขตกรุงเทพฯ และจังหวัดนนทบุรี จำนวน 12 ตัวอย่าง สำนักงานสาธารณสุขจังหวัดสระบุรี เก็บจากอำเภอมวกเหล็ก จำนวน 3 ตัวอย่าง รวมทั้งหมด 15 ตัวอย่าง มาทำการตรวจวิเคราะห์คุณภาพทางเคมี เมื่อวันที่ 24 พฤษภาคม 2559

โดยผลการตรวจวิเคราะห์คุณภาพทางเคมี จาก 15 ตัวอย่าง ไม่ผ่านเกณฑ์ตามที่กฎหมายกำหนด 2 ตัวอย่าง พบว่ามีการใช้วัตถุกันเสีย 6 ตัวอย่าง ซึ่งมีเพียง 1 ตัวอย่างที่ใช้วัตถุกันเสียเกินกว่าที่กฎหมายกำหนด และมีการใช้สารให้ความหวานแทนน้ำตาลชนิดซัคคาริน จำนวน 4 ตัวอย่าง ซึ่งต่ำกว่าที่กฎหมายกำหนด สำหรับตัวอย่างที่เก็บจากจังหวัดสระบุรี จำนวน 3 ตัวอย่าง ตรวจพบซัคคาริน และสีสังเคราะห์ในทุกตัวอย่าง แต่สีที่ตรวจพบเป็นสีสังเคราะห์ที่อนุญาตให้ใช้ มี 1 ตัวอย่างที่ใช้ปริมาณสีเกินเกณฑ์กำหนด
สำหรับการตรวจคุณภาพทางจุลชีววิทยา 15 ตัวอย่าง ไม่ผ่านเกณฑ์มาตรฐานทุกตัวอย่าง เนื่องจากตรวจพบจุลินทรีย์บ่งชี้สุขลักษณะเกินมาตรฐาน คือ ตรวจพบปริมาณยีสต์และราเกินในทุกตัวอย่าง พบโคลิฟอร์มเกินมาตรฐาน 9 ตัวอย่าง และพบอีโคไล 6 ตัวอย่าง แต่ทุกตัวอย่างไม่พบการปนเปื้อนเชื้อโรคอาหารเป็นพิษ
ทั้งนี้นายแพทย์อภิชัย กล่าวเพิ่มเติมว่า โดยปกติแล้วน้ำส้มคั้นสด ๆ ถ้าตั้งทิ้งไว้จะมีตะกอนเนื้อส้มอยู่ด้านล่าง หากไม่มีตะกอนเป็นน้ำสีส้มใส ๆ อาจเป็นน้ำส้มผสม อย่างไรก็ตามให้ลองดมกลิ่นก่อน ถ้าเป็นน้ำส้มคั้นสดจะมีกลิ่นส้มธรรมชาติ หากไม่มีกลิ่นหรือกลิ่นจางจะไม่ใช่น้ำส้มคั้นสด เพราะน้ำส้มคั้นสดต้องมีสี กลิ่น รสตามธรรมชาติ หากดื่มแล้วมีรสชาติแปลก ๆ ควรทิ้งไป
ติดตามข่าว น้ำส้มปลอม ทั้งหมด คลิกเลย
ภาพและข้อมูลจาก กรมวิทยาศาสตร์การแพทย์





